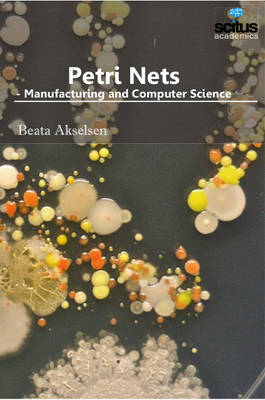
Petri Nets

Essays in Honour of Amilcar Sernadas
Buch | Softcover
2017
|
College Publications
ISBN: 9781848902480
CHF 41,80 (inkl. MwSt)
- Titel nicht im Sortiment